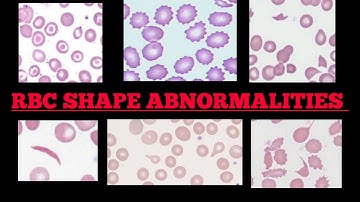
RBC Shape Abnormalities In Peripheral 🩸Blood Smear | Made Easy | Images

⬇ DOWNLOAD NOW
Jika muncul iklan pop-up, tutup lalu klik tombol kembali
Download lagu Review on Identification of Red Blood Cells by Image Processing secara gratis hanya untuk keperluan promosi. Dukung artis favorit kamu dengan membeli musik original di iTunes atau platform resmi lainnya.
 Studies on Red Blood Cells (RBCs) and White Blood Cells (WBCs) Detection by Image Processing
Studies on Red Blood Cells (RBCs) and White Blood Cells (WBCs) Detection by Image Processing The Components of Blood and Their Importance
The Components of Blood and Their Importance counting of Red Blood Cells and White Blood Cells using image processing
counting of Red Blood Cells and White Blood Cells using image processing Image processing of video of RBC flow
Image processing of video of RBC flow Human Blood Video | Blood Components | Blood Cells
Human Blood Video | Blood Components | Blood Cells Counting Red Blood Cell-Image Processing-2022
Counting Red Blood Cell-Image Processing-2022 Detection and counting of blood cells using image segmentation A review
Detection and counting of blood cells using image segmentation A review RBC Shape Abnormalities In Peripheral 🩸Blood Smear | Made Easy | Images
RBC Shape Abnormalities In Peripheral 🩸Blood Smear | Made Easy | Images